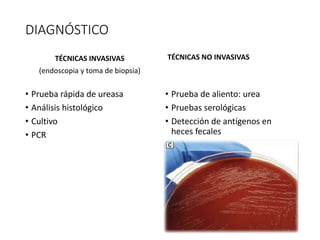
DIAGNÓSTICO
TÉCNICAS INVASIVAS
(endoscopia y toma de biopsia)
• Prueba rápida de ureasa
• Análisis histológico
• Cultivo
• PCR
TÉCNICAS NO INVASIVAS
• Prueba de aliento: urea
• Pruebas serológicas
• Detección de antígenos en
heces fecales

1) Campylobacter y Helicobacter son bacterias gramnegativas que causan enfermedades gastrointestinales en humanos y animales.
2) Campylobacter jejuni es la causa más común de diarrea bacteriana en países desarrollados, mientras que Helicobacter pylori infecta crónicamente el estómago y puede causar úlceras pépticas, cáncer gástrico y linfoma.
3) El diagnóstico se realiza mediante aislamiento microbiológico e identificación bioquímica de las bacterias